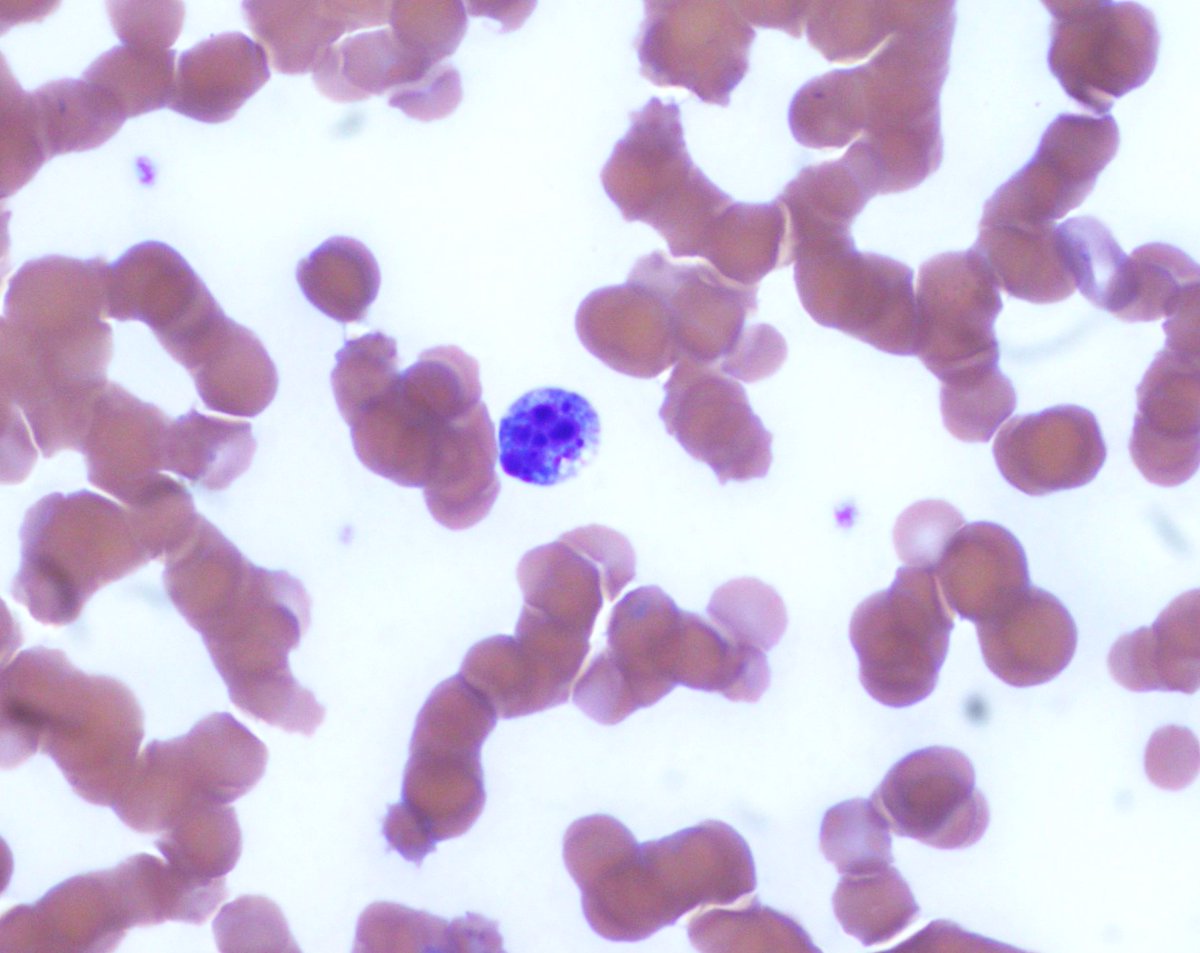
NYUGSOM Pathology Residency tweet media
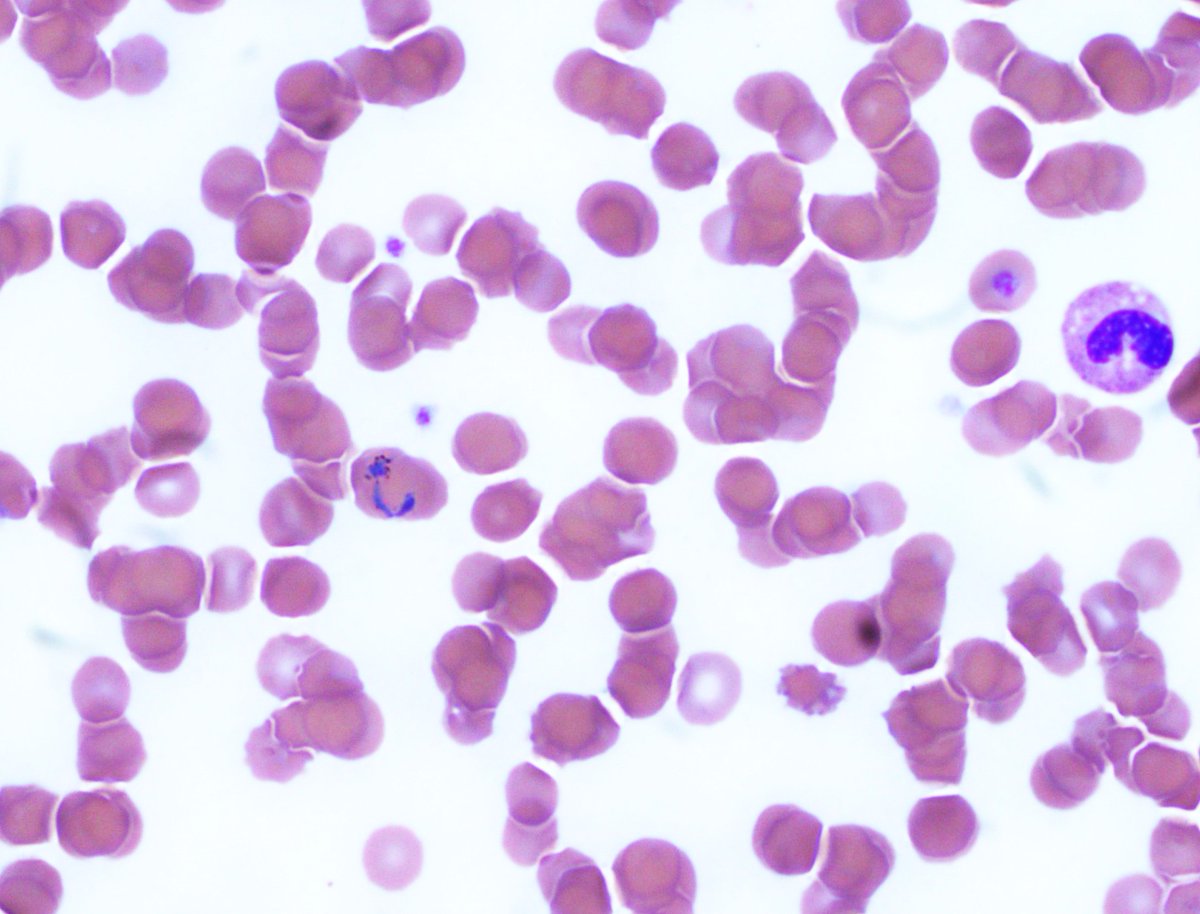
NYUGSOM Pathology Residency tweet media

Mark Strong🔬
2.1K posts

Mark Strong🔬
@markstrong95
PGY-3 AP/CP Resident @NYUGSOMpathres - 🌈🏳️🌈 (he/him)
Beigetreten Ağustos 2016
707 Folgt695 Follower


Congrats to Mark, our superstar this year, for a great platform presentation!!! So proud of you!!!!!
NYUGSOM Pathology Residency@NYUGSOMpathres
Congrats to Dr. Mark Strong for his platform presentation in the quality and patient safety session and poster on digital versus glass grading in clear cell renal cell carcinoma at #USCAP2026 🎤💜 @NYUGSOM_Path #NYUPathology
San Antonio, TX 🇺🇸 English
Mark Strong🔬 retweetet

just published—out now!
collision tumors are already RARE
& this example presented in the
most uncommon of ways as a
metastatic lung adenocarcinoma
involving a leiomyosarcoma of the leg
doi.org/10.1177/106689…
#bstpath #thoracicpath
#pathtwitter

English
Mark Strong🔬 retweetet

Congrats to Dr. Mark Strong for his platform presentation in the quality and patient safety session and poster on digital versus glass grading in clear cell renal cell carcinoma at #USCAP2026 🎤💜 @NYUGSOM_Path #NYUPathology



English

@NYUGSOMpathres @NYUGSOM_Path Congrats all! We are excited to have you
English
Mark Strong🔬 retweetet

We are excited to welcome our incoming NYUGSOM Pathology PGY1s for 2026! The future is so BRIGHT and we are so excited to have all of you!
#MatchDay2026 #PathMatch26 @NYUGSOM_Path

English
Mark Strong🔬 retweetet

Today on World Pancreatic Cancer Day, we recognize our incredible #NYU GI pathologists and PAs who play a vital role in diagnosing these complex diseases. Thank you to our wonderful team for their expertise, dedication, and commitment to patient care.💜#WorldPancreaticCancerDay



English
Mark Strong🔬 retweetet

Happy new (academic) year!! July kicks off the start of new intern classes across the country, including our new @nyugsom_path PGY1 residents! We are so excited to welcome them to our path family ❤ Stay tuned for highlights from their #pathology bootcamp this month! #pathtwitter


English
Mark Strong🔬 retweetet

@nyrr There are no more non medical spots for anything? I got in right at 12 and waited 10 mins before getting in
English

@NYUGSOMpathres Congrats everyone! Can't wait to work with all of you
English
Mark Strong🔬 retweetet

A big welcome to our new NYU pathology residents!! We’re thrilled to have you join us and can’t wait to support you as you grow. Excited to see all the amazing things you'll accomplish in your journey ahead! #Match2025 #PathMatch2025 #PathX #PathTwitter

English
Mark Strong🔬 retweetet

✨🚨 Calling all future pathologists! 🚨✨ Join us for the NYU ODA Virtual Open House!
🗓 September 11th
🕕 6:00 PM - 8:00 PM EST
📍 Zoom: forms.gle/4A2ZGk2v1MuySL… (Links will be sent after registration)
6:00-6:30 PM: Welcome & DEI highlights
7:00-8:00 PM: Pathology breakout rooms

English

Congrats to our faculty and residents representing us at the @ASCP_Chicago #ASCP2024 annual meeting. A special shoutout to Henry Wu, PGY-2, for being a blue ribbon finalist with his outstanding poster! 🏅🔬👏 #pathology #pathtwitter @NYUGSOM_Path


English
Mark Strong🔬 retweetet
Mark Strong🔬 retweetet

Happy new (academic) year!! July kicks off the start of new intern classes across the country, including our new @nyugsom_path PGY1 residents! We are so excited to welcome them to our path family ❤ Stay tuned for highlights from their #pathology bootcamp this month! #pathtwitter

English
Mark Strong🔬 retweetet

Check out this blood smear for Plasmodium vivax - can you discern the developmental stages in these photos? Thanks to our @NYUGSOM_Path resident Jake for sharing this case. 🦠🔬 #Pathology #Pathtwitter #Pathoutpic

English

@NYUGSOMpathres @NYUGSOM_Path Welcome! Excited to have all of you 🔬💙
English

Please join us in congratulating our #Pathmatch24 incoming PGY-1 class! We are proud to have you in our @NYUGSOM_Path Pathology family! Welcome to New York 🗽#PathTwitter #PathMatch24 #PathMatch2024 #path2path

English

Got my #1!!! 😭😭😭 Couldn't believe it!! Can't wait to meet my corezzzies!!!!
NYUGSOM Pathology Residency@NYUGSOMpathres
Please join us in congratulating our #Pathmatch24 incoming PGY-1 class! We are proud to have you in our @NYUGSOM_Path Pathology family! Welcome to New York 🗽#PathTwitter #PathMatch24 #PathMatch2024 #path2path
English









